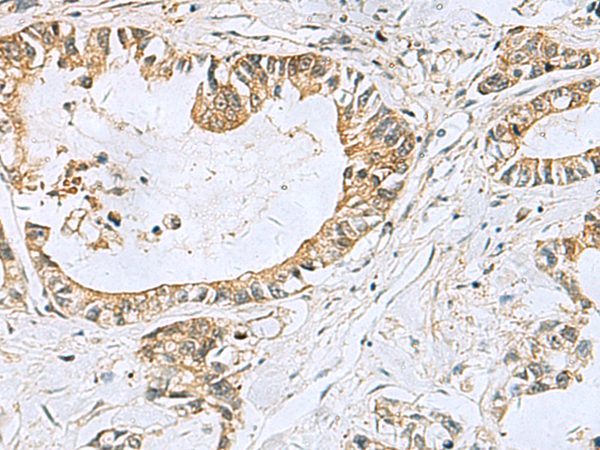
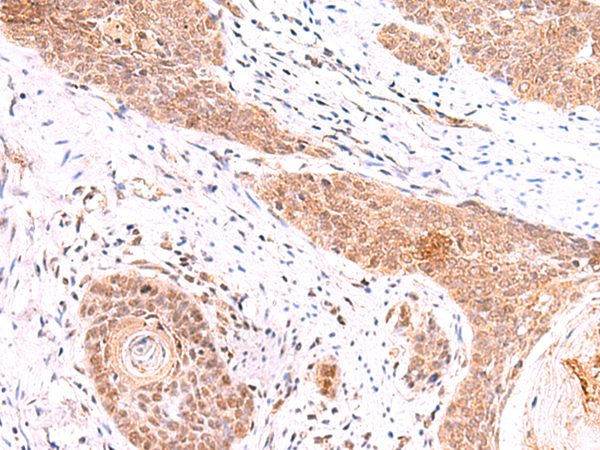

-
分类: 科研抗体货号: P10155别名: ACTL6; BAF53B; arpNalpha应用: WB,IHC反应种属: Human, Mouse, Rat
-
分类: 科研抗体货号: P10127别名: SLy2; HACS1; NASH1; SASH2; SH3D6B应用: WB,IHC反应种属: Human, Mouse
-
分类: 科研抗体货号: P10143别名: LAL; CESD应用: IHC反应种属: Human
-
分类: 科研抗体货号: P10154别名: AT; AGAT; CCDS3应用: IHC反应种属: Human, Mouse, Rat
-
分类: 科研抗体货号: P10142别名: TUBD应用: WB,IHC反应种属: Human, Mouse
-
分类: 科研抗体货号: P10153别名: CSN3; SGN3应用: WB,IHC反应种属: Human, Mouse, Rat
-
分类: 科研抗体货号: P10174别名: LAP1; LAP1B; LGMD2Y应用: IHC反应种属: Human, Mouse, Rat
-
分类: 科研抗体货号: P10152别名: ISC1; NSMASE; NSMASE1应用: WB,IHC反应种属: Human, Mouse, Rat
-
分类: 科研抗体货号: P10173别名: HBI; p52; Hsp56; FKBP51; FKBP52; FKBP59; PPIase应用: WB,IHC反应种属: Human, Mouse, Rat
-
分类: 科研抗体货号: P10151别名: AK 9; AKD1; AKD2; C6orf199; C6orf224; dJ70A9.1应用: IHC反应种属: Human

鄂公网安备42018502007531号
鄂公网安备42018502007531号

